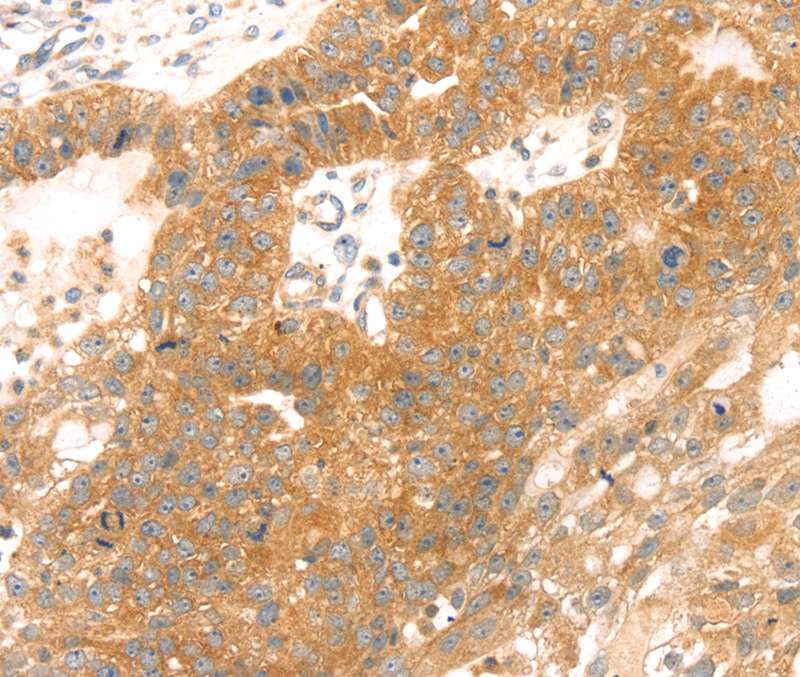

Tomoregulin 2 Antibody (YA2035)
HY-P82290
TargetTMEFF2
Product group Antibodies
Overview
- SupplierMedChem Express
- Product NameTomoregulin 2 Antibody (YA2035)
- Delivery Days Customer5
- CertificationResearch Use Only
- ClonalityMonoclonal
- Gene ID23671
- Target nameTMEFF2
- Target descriptiontransmembrane protein with EGF like and two follistatin like domains 2
- Target synonymscancer/testis antigen family 120, member 2; CT120.2; HPP1; hyperplastic polyposis protein 1; TENB2; tomoregulin-2; TPEF; TR; TR-2; transmembrane protein TENB2; transmembrane protein with EGF-like and two follistatin-like domains
- HostRabbit
- IsotypeIgG
- Scientific DescriptionTomoregulin 2 Antibody (YA2035) is a rabbit-derived non-conjugated IgG antibody (Clone NO.: YA2035), targeting Tomoregulin 2, with a predicted molecular weight of 41 kDa (observed band size: 41 kDa). Tomoregulin 2 Antibody (YA2035) can be used for WB, IHC-P, ICC/IF, FC experiment in human background.
- UNSPSC12352203